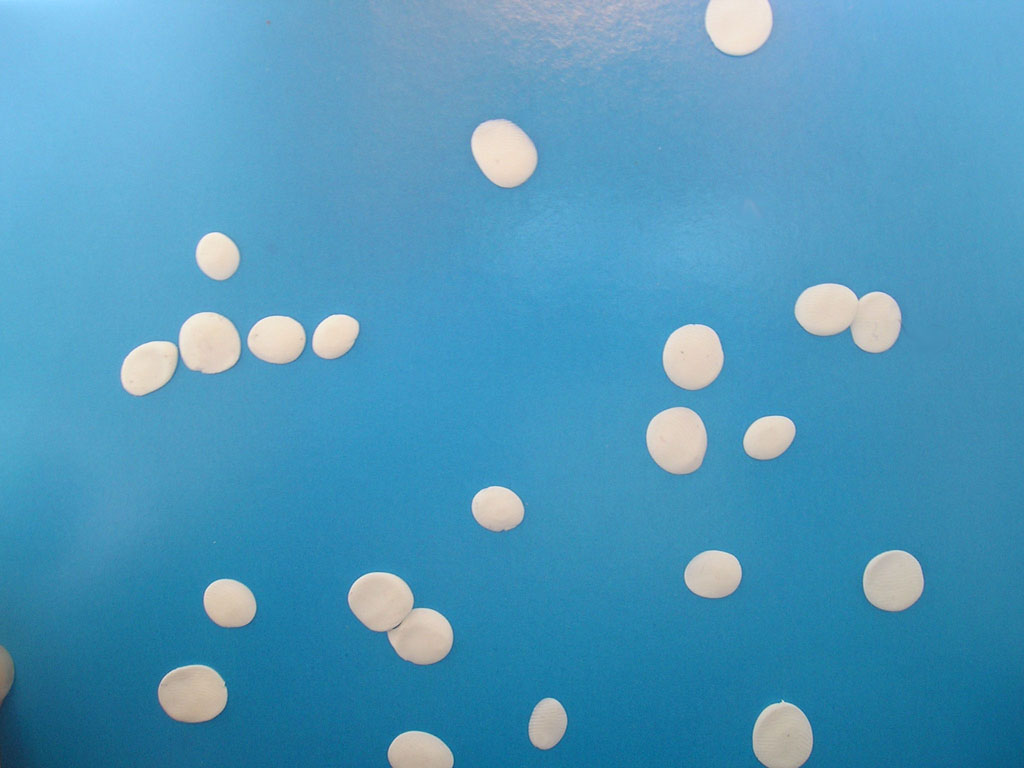

Первый снег
Беру в ладони первый снег,
Холодный, чистый, серебристый,
Как будто белый нежный мех,
Воздушный, мягкий и пушистый.
Со мною рядом малыши,
Из снега лепят Буратино.
И все смеются от души.
Уже, начав, ваять Мальвину.
И я, забыв про все дела,
В игру включилась тоже с ними.
Губной помадой провела,
По губкам маленьким Мальвины.
И вот в меня снежки летят,
Смеющихся, других прохожих.
И каждый снегу очень рад,
И все вдруг стали, чуть моложе!
Свидетельство о публикации №111103107421
Гульжиган Гайнуллина 19.11.2011 22:42 • Заявить о нарушении
Людмила Ойкина 20.11.2011 00:38 Заявить о нарушении